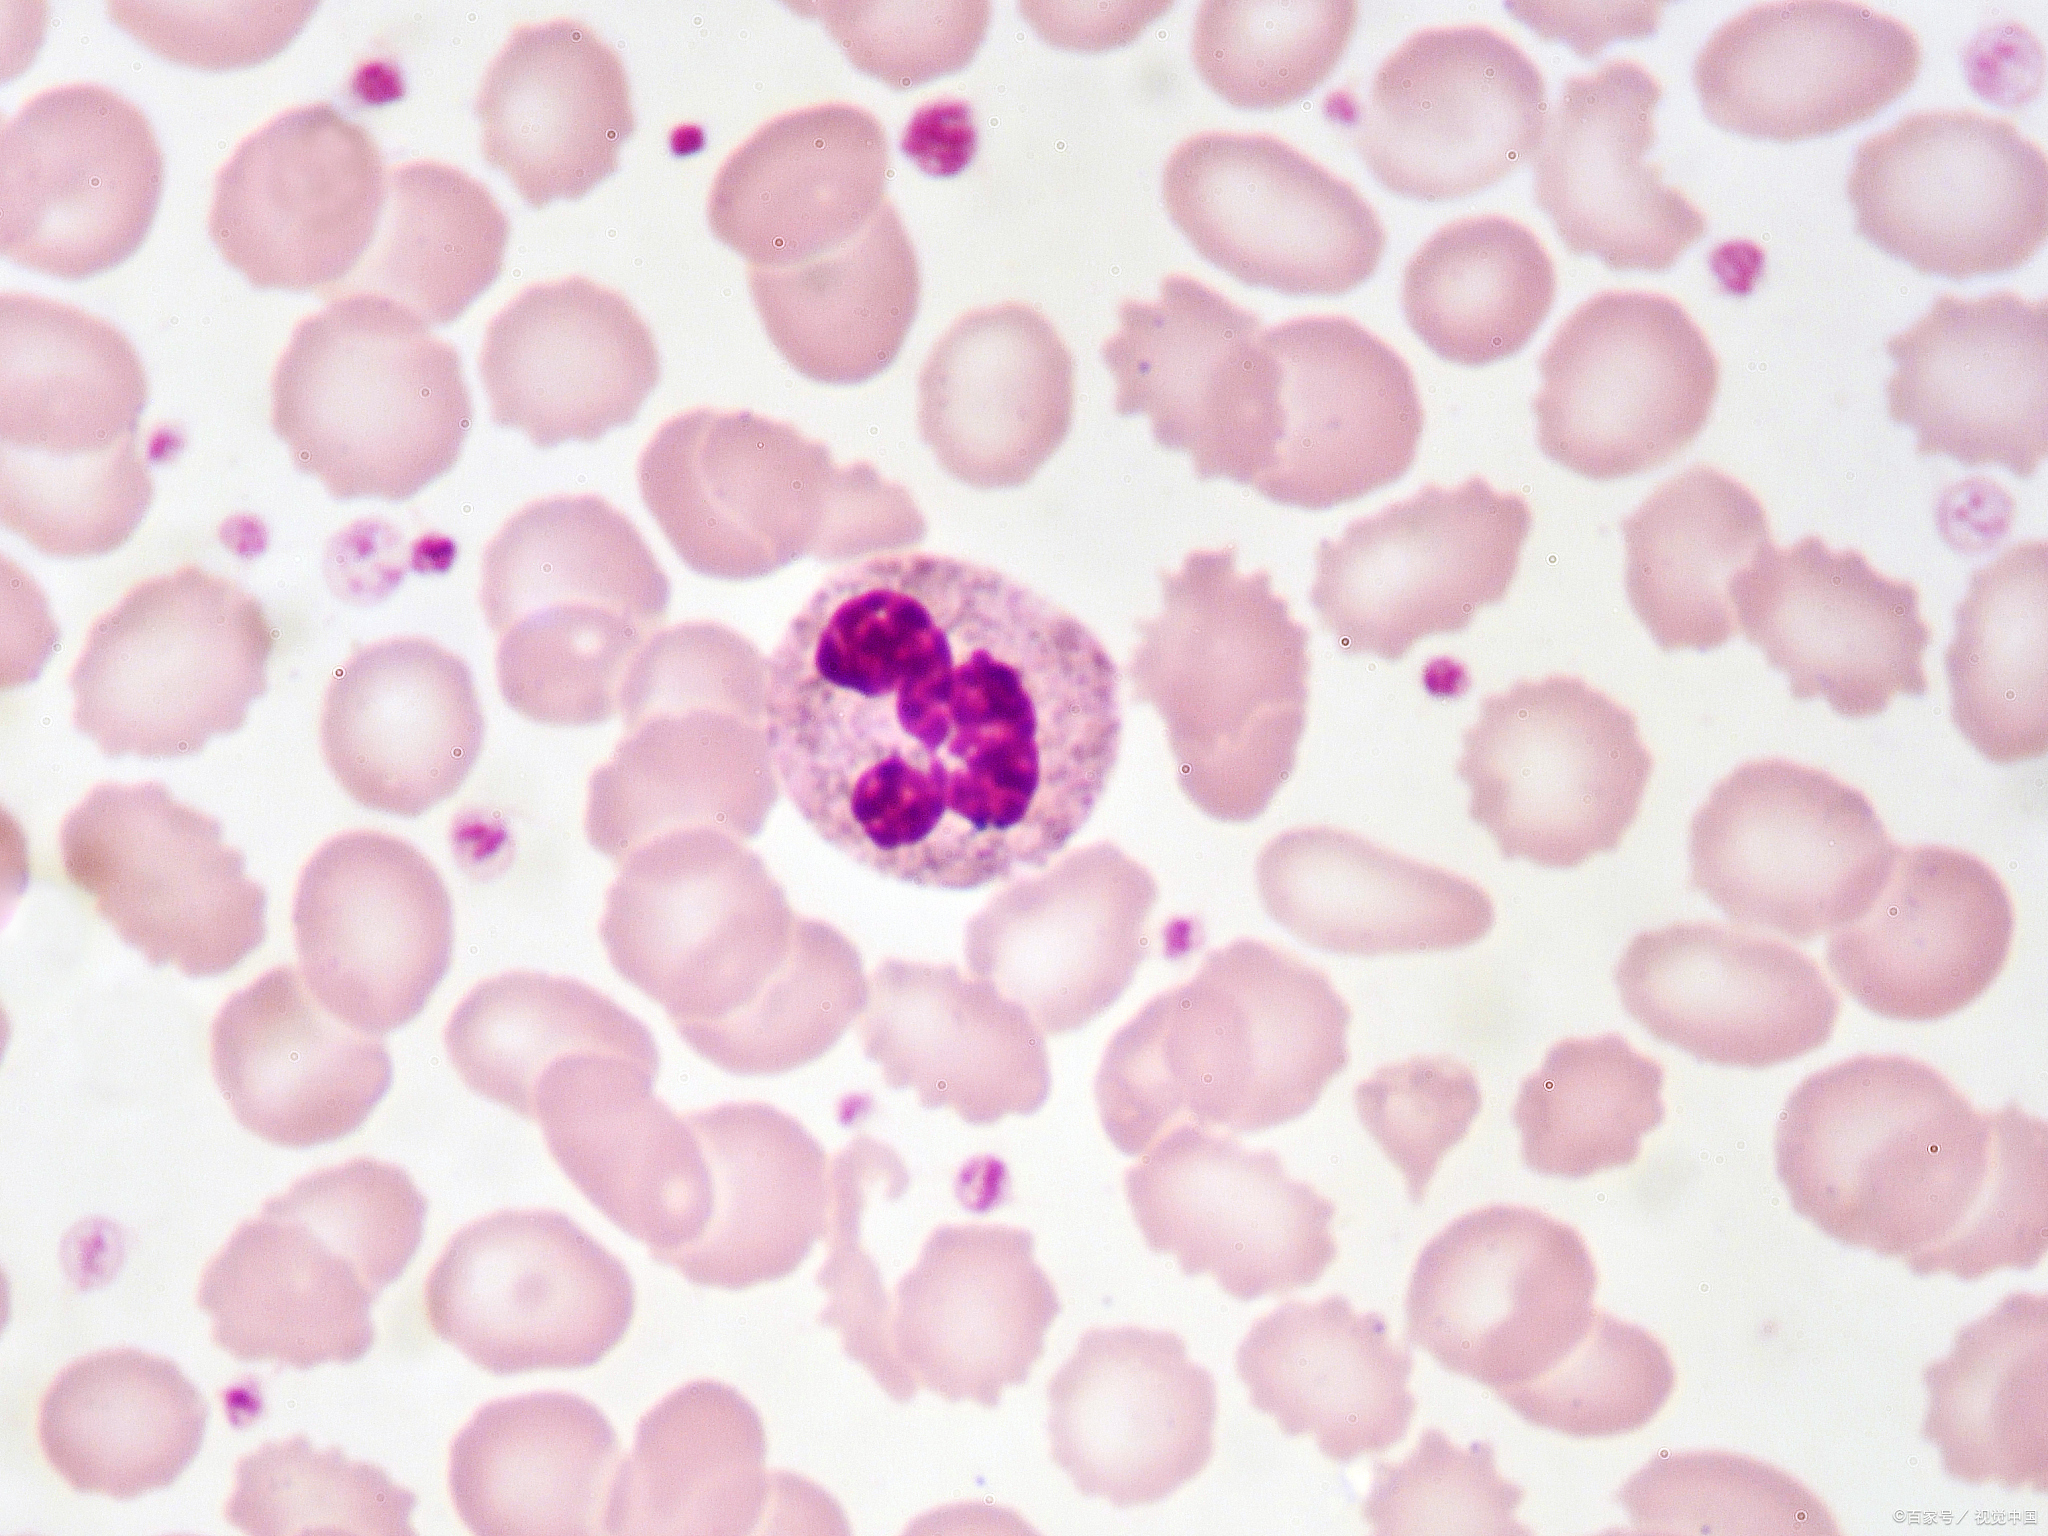
嗜碱性粒细胞明显升高

组织嗜碱细胞图片

肥大细胞或组织嗜碱细胞——血细胞形态学
图片尺寸903x1205
嗜碱性粒细胞 成熟嗜碱性粒细胞:胞核可见分叶或轮廓不清,胞质内和
图片尺寸1920x2505
检验图谱 | 嗜碱性粒细胞(2)
图片尺寸660x502
嗜碱性粒细胞明显升高
图片尺寸2048x1536
嗜碱性粒细胞篇
图片尺寸1080x1439
上海富衡 | 嗜碱性粒细胞是什么?
图片尺寸640x360
细胞形态|图谱and自拍|嗜酸|嗜碱
图片尺寸1169x1394
今天找了将近一个小时的嗜碱性粒细胞!
图片尺寸1027x828
cnsl脑脊液中的嗜碱性粒细胞
图片尺寸534x534
上海富衡 | 嗜碱性粒细胞是什么?
图片尺寸640x512
2️⃣细胞核多分为2叶,呈眼镜状,深紫红色 🌒嗜碱性粒细胞 1
图片尺寸1137x1538
组织嗜碱细胞肥大细胞请报告箭头所指细胞内物质的名称豪若小体未完
图片尺寸379x260
兽医打工日常😸非常罕见的嗜碱性粒细胞‼️ 😸😸做了个血
图片尺寸1920x1440
嗜碱性粒细胞:身体里的"碱性小顽童"!
图片尺寸1242x1660
看图识细胞(第50期)_圆形
图片尺寸720x827
检验图谱 | 嗜碱性粒细胞(2)
图片尺寸660x502
前4张 嗜碱 嗜酸 俩分叶边上都有蓝斑 白细胞胞浆有异常包涵 - 抖音
图片尺寸1920x1442
检验图谱 | 嗜碱性粒细胞(2)
图片尺寸660x502
检验图谱 | 嗜碱性粒细胞(2)
图片尺寸660x502
嗜碱性粒细胞#形态学介绍 嗜碱性粒细胞介绍 嗜碱性粒细胞(basophil
图片尺寸1280x800